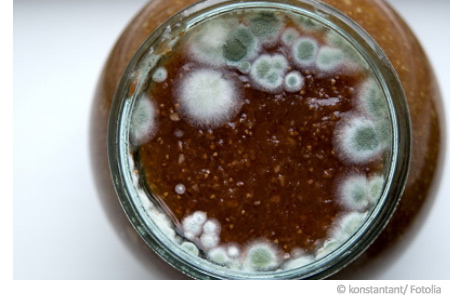

Schimmelsporen
Schimmel bilden zur Überdauerung, Verbreitung und Fortpflanzung Sporen aus. So werden einerseits durch Schimmel Sporen produziert, um nachteilige chemische, thermische oder trockene Lebensbedingungen trotz des Absterbens des Myzels zu überstehen. Andererseits dienen die Schimmelsporen dazu, um durch Luftübertragung neue Lebensräume zu erreichen. Schimmelsporen sind vergleichsweise winzig, mit dem bloßen Auge sind sie nicht zu erkennen. Sie sind steter Bestandteil der Außenluft, wobei es zu saisonalen Unterschieden kommt, je nachdem, welche Schimmelgattung aktuell vermehrt Sporen aussendet. Manche Schimmel können die Sporen auf sexuelle und zugleich asexuelle Weise bilden. Die meisten Schimmelpilze bilden die Sporen aber in Form von sogenannten Kondiden (asexuelle Fruchtform) aus.
Bunt und gefährlich: Schimmelsporen auf Wänden
Wenn Schimmel an den Wänden farbig in Erscheinung treten, hängt dies mit in den Konidien eingelagerten Farbstoffen zusammen. Die Sporen der Schimmelpilze sind nämlich häufig durch eingelagerte Pigmente gegen UV-Licht geschützt. Wenn wir eine Schimmelbildung auf Wandflächen beobachten, ist also nicht das eigentliche Pilzmyzel zu erkennen, sondern die auffällig gefärbten Sporen der Schimmelpilze. Wenn Sie Schimmelflecken von einer Wand entfernen möchten, stellen die Schimmelsporen eine Gefahrenquelle bei der Sanierung dar: Besonders dann, wenn scheinbar abgestorbene Schimmelpilze trocken entfernt, also nur mit einer Bürste abgetragen werden, kann die Konzentration der Schimmelsporen in der Luft durch Freisetzung und Verwirbelung um mehr als das tausendfache ansteigen.
Schimmelsporen als Gesundheitsrisiko
Das Einatmen von Schimmelsporen kann schädliche Auswirkungen auf die Gesundheit haben. So ist es bekannt, dass Schimmelsporen Allergien auf Schimmelpilze auslösen oder bestehende Allergien gegen andere Substanzen verstärken können. Ebenfalls problematisch ist eine durch die Sporen von Schimmelpilzen oft beobachtete Reizung der Atemwege, oder ein durch den Aufenthalt in stark belasteten Räumen ausgelöstes Gefühl von allgemeinem Unwohlsein. In dieser Beziehung gibt es einen Zusammenhang zwischen hohen Konzentrationen von Schimmelsporen in der Raumluft und dem Auftreten des sogenannten Sick-Building-Syndroms. Desweiteren gefährden die Sporen als Träger von Schimmelpilzgiften (Mykotoxinen) die Gesundheit. Bei längerfristigem Aufenthalt in stark belasteteten Räumen drohen zumindest geschwächten Personen chronische Vergiftungen und sogar die Entstehung von Krebs.
Sicherheitsmaßnahmen gegen Schimmelsporen
➥
Die Sporen von Schimmelpilzen sind allgegenwärtig in der Luft
vertreten. Erst durch hohe Konzentrationen drohen Gesundheitsgefahren.
Achten Sie also darauf, Räume ohne konkrete Schimmelbelastungen zu
bewohnen.
➥ Tragen Sie bei jeder Entfernung eines Schimmelbefalls einen geeigneten Atemschutz!
➥
Vorsicht: Bei der Entfernung werden größte Mengen an Sporen
freigesetzt. Treffen Sie Vorkehrungen, um eine Verbreitung der Sporen in
andere Räume zu verhindern und entfernen Sie stoffbezogene Möbelstücke
vor Beginn der Maßnahme aus dem betroffenen Raum.
➥ Halten Sie generell Sauberkeit: Häufig finden sich Schimmelsporen im Staub!
✔️ Bis zu 6 Räume
✔️ Original airself
✔️ Schimmelpilzgattungen
✔️ Belastungseinschätzung
✔️ Schimmelpilzgattungen
✔️ Für verdächtige Stellen